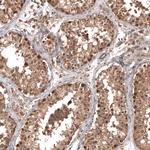
OTUB1 Antibody in Immunohistochemistry (Paraffin) (IHC (P))

Search
Invitrogen
OTUB1 Polyclonal Antibody
{{$productOrderCtrl.translations['antibody.pdp.commerceCard.promotion.promotions']}}
{{$productOrderCtrl.translations['antibody.pdp.commerceCard.promotion.viewpromo']}}
{{$productOrderCtrl.translations['antibody.pdp.commerceCard.promotion.promocode']}}: {{promo.promoCode}} {{promo.promoTitle}} {{promo.promoDescription}}. {{$productOrderCtrl.translations['antibody.pdp.commerceCard.promotion.learnmore']}}

Please note: We are reviewing Western blot images included in the antibody testing data in our catalog, including those provided by third parties. Unless expressly labeled or annotated as “raw-unedited”, Western blot images included in the antibody testing data in our catalog may have been edited, optimized or otherwise adjusted for presentation.
产品信息
PA5-58684
种属反应
已发表种属
宿主/亚型
分类
类型
抗原
偶联物
形式
浓度
规格
纯化类型
保存液
内含物
保存条件
运输条件
RRID
产品详细信息
Immunogen sequence: AAEEPQQQKQ EPLGSDSEGV NCLAYDEAIM AQQDRIQQEI AVQNPLVSER LELSVLYKEY AEDDNIYQQK IKDLHKKYSY IRKTRPD
Highest antigen sequence identity to the following orthologs: Mouse - 100%, Rat - 100%.
靶标信息
The product of this gene is a member of the OTU superfamily of predicted cysteine proteases. The encoded protein is a highly specific ubiquitin iso-peptidase, and cleaves ubiquitin from branched poly-ubiquitin chains but not from ubiquitinated substrates. It interacts with another ubiquitin protease and an E3 ubiquitin ligase that inhibits cytokine gene transcription in the immune system. It is proposed to function in specific ubiquitin-dependent pathways, possibly by providing an editing function for polyubiquitin chain growth. Alternative splicing results in multiple transcript variants.
仅用于科研。不用于诊断过程。未经明确授权不得转售。
生物信息学
蛋白别名: Deubiquitinating enzyme OTUB1; deubiquitinating enzyme OTUB1 {ECO:0000250|UniProtKB:Q7TQI3}; FLJ20113; FLJ40710; hOTU1; MGC111158; MGC4584; OTU domain, ubiquitin aldehyde binding 1; OTU domain-containing ubiquitin aldehyde-binding protein 1; OTU domain-containing ubiquitin aldehyde-binding protein 1 {ECO:0000250|UniProtKB:Q7TQI3}; otub1 {ECO:0000312|EMBL:AAI66771.1}; otubain 1; Otubain-1; otubain-1 {ECO:0000250|UniProtKB:Q7TQI3}; Ubiquitin thioesterase OTUB1; ubiquitin thioesterase OTUB1 {ECO:0000250|UniProtKB:Q7TQI3}; Ubiquitin-specific-processing protease OTUB1; ubiquitin-specific-processing protease OTUB1 {ECO:0000250|UniProtKB:Q7TQI3}
基因别名: AI850305; HSPC263; OTB1; OTU1; OTUB1
UniProt ID: (Mouse) Q7TQI3, (Rat) B2RYG6
Entrez Gene ID: (Mouse) 107260, (Rat) 293705




